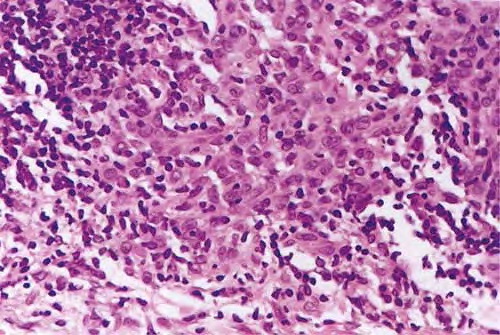
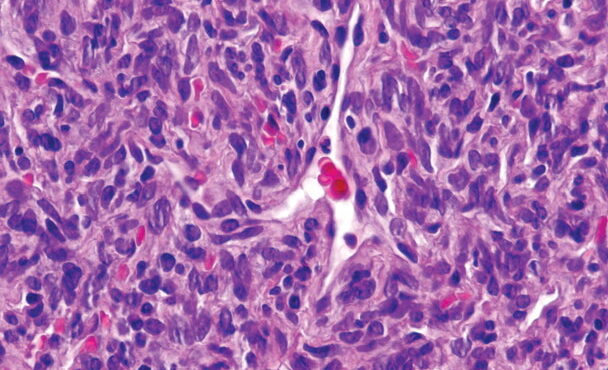
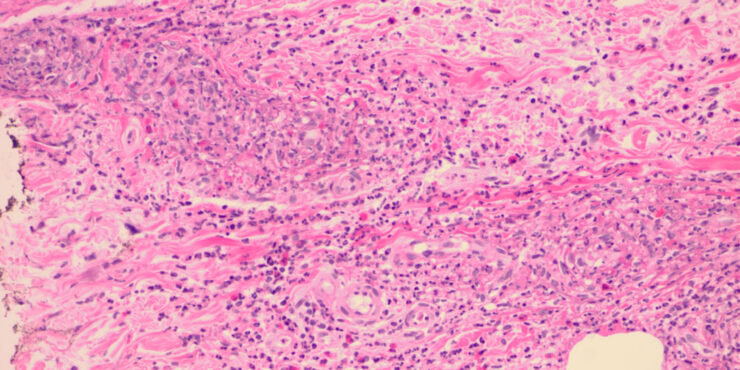

Hailey Hailey disease= ุงูููุงุน ุงูุนุงุฆูู ุงูุณููู ูููู ูููู
Hailey Hailey disease= ุงูููุงุน ุงูุนุงุฆูู ุงูุณููู ูููู ูููู HaileyHailey Disease Familial benign pemphigus is inherited as an autosomal dominant trait, with a family history obtainable in about two thirds of patients. Genetic studies have localized the key mutations to the ATP2C1 gene on chromosome 3q , specifically 3q21-q24, the area responsible for ATP-dependent calcium transport […]
Read More